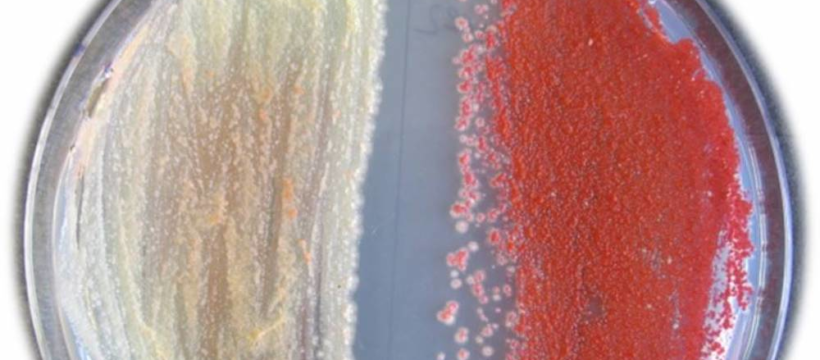

DSMZ-Wissenschaftlerin entwickelt innovative Strategie für das Screening nach Wirkstoffen
Forschende rund um Professorin Dr. Yvonne Mast vom Leibniz-Institut DSMZ-Deutsche Sammlung von Mikroorganismen und Zellkulturen im niedersächsischen Braunschweig haben eine neue Strategie zur Aktivierung stiller Antibiotika-Gencluster entwickelt. Sie zeigten, dass sich das Streptomyces Antibiotic Regulatory Protein (SARP), ein Regulator, der die Biosynthese von Antibiotika in Streptomyceten reguliert, als genereller Aktivator verschiedener Antibiotika-Gencluster einsetzen lässt. Wie mit Hilfe der SARPs aktivierbare Gencluster identifiziert und gezielt angeschaltet werden können, veröffentlichten die Forschenden in der international renommierten Fachzeitschrift Frontiers in Microbiology.
In der Studie konnte das Team um die Mikrobiologin Yvonne Mast zeigen, dass SARP-Regulatoren in vielen verschiedenen Actinomyceten vorkommen und dort Bestandteil von Genclustern sind, die für ganz unterschiedliche Wirkstofftypen kodieren. In ihren Experimenten wiesen die Forschenden nach, dass die SARP-Regulatoren das Potenzial haben, auch Gencluster in anderen Wirtsstämmen zu regulieren. Am Beispiel des SARP-Regulators PapR2 wurde gezeigt, dass dieser nicht nur in dem Bakterium Streptomyces pristinaespiralis, in dem er natürlicherweise vorkommt, Cluster-aktivierende Eigenschaften hat. Er ist auch in der Lage, in anderen Streptomyceten wie beispielsweise Streptomyces lividans stille Gencluster zu aktivieren und damit die Wirkstoffproduktion erst zu ermöglichen. Durch ein besseres Verständnis der Regulationsmechanismen und mit Hilfe von Genomsequenzdaten können die Forschenden nun vorhersagen, welche Gencluster sich potentiell durch SARPs aktivieren lassen was die spätere Findung der Wirkstoffe erleichtert.
Aktivierung stiller Gencluster
Actinomyceten sind bekannt für ihr Potential zur Produktion vieler bioaktiver Wirkstoffe. Durch Genomsequenzanalysen ist bekannt, dass die Organismen zahlreiche sogenannte „stille Gencluster“ beherbergen, welche die Information für Wirkstoffsynthesen enthalten, die aber nicht in die entsprechenden Substanzen übersetzt wird. Es wird angenommen, dass Actinomyceten theoretisch zehnmal mehr Sekundärmetabolite produzieren könnten als normalerweise unter Standardlaborbedingungen isoliert werden. Warum viele der Cluster „inaktiv“ sind ist bislang unklar. Ein Grund könnte aber die fehlende Aktivierung durch regulatorische Elemente sein. Das Auffinden und Aktivieren solcher stillen Gencluster und die daraus resultierende Identifizierung und Charakterisierung neuer potentieller Wirkstoffe sind in Zeiten der Zunahme von Infektionen mit antibiotikaresistenten Pathogenen von größter Bedeutung. „Der Vorteil der von uns genutzten Methode ist, dass man damit relativ einfach aber zielgerichtet Gencluster aktivieren kann. Die meisten anderen Strategien zur Aktivierung stiller Gencluster sind unspezifische Aktivierungsansätze, die in der chemischen Analytik aufwendig sind oder aber Gencluster-spezifische Ansätze, die dann mit viel Klonierungsaufwand verbunden sind.“ fasst Professorin Yvonne Mast die Vorteile ihres Forschungsansatzes zusammen.
Die DSMZ ist eines der größten Bioressourcenzentren weltweit. Die Sammlung umfasst derzeit über 67.000 Kulturen, einschließlich über 35.000 verschiedene Bakterien- und 4000 Pilz-Stämme, 800 menschliche und tierische Zelllinien, 41 Pflanzenzelllinien, 1.400 Pflanzen-Viren und Antiseren und 13.000 verschiedene Typen genomischer Bakterien-DNA.
Kontakt
Leibniz-Institut DSMZ-Deutsche Sammlung von Mikroorganismen und Zellkulturen
Sven-David Müller
Inhoffenstraße 7 B
38124 Braunschweig
0531-5312616300
sven.david.mueller@dsmz.de
http://www.dsmz.de
Die Bildrechte liegen bei dem Verfasser der Mitteilung.